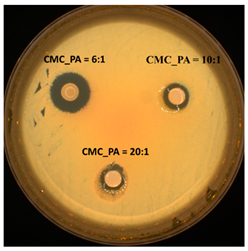
Gels 08 00647 i001
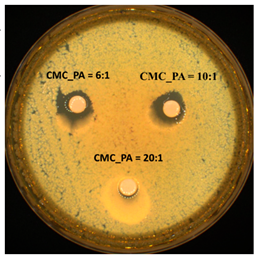
Gels 08 00647 i002

One-Step Preparation of Carboxymethyl Cellulose—Phytic Acid Hydrogels with Potential for Biomedical Applications
Abstract
1. Introduction
2. Results and Discussions
2.1. FTIR Spectroscopy Analysis
2.2. Swelling Tests
2.3. Rheological Studies
2.4. Scanning Electron Microscopy Analysis
2.5. Thermal Behavior
2.6. In Vitro Studies of Procaine Release
2.7. In Vitro Biocompatibility Assay
2.8. Antimicrobial Activity
3. Conclusions
4. Materials and Methods
4.1. Materials
4.2. Sample Preparation
4.2.1. Preparation of CMC/PA Hydrogels
4.2.2. Preparation of Procaine-Loaded CMC/PA Hydrogels
4.3. Characterization
4.3.1. FTIR Spectroscopy
4.3.2. Swelling Tests
4.3.3. Rheological Studies
4.3.4. Scanning Electron Microscopy (SEM) Analysis
4.3.5. Thermal Analysis
4.3.6. In Vitro Studies of Procaine Release
4.3.7. In Vitro Biocompatibility Assay
4.3.8. Antimicrobial Activity
Author Contributions
Funding
Institutional Review Board Statement
Data Availability Statement
Conflicts of Interest
References
- Rahman, M.S.; Hasan, M.S.; Nitai, A.S.; Nam, S.; Karmakar, A.K.; Ahsan, M.S.; Shiddiky, M.J.A.; Ahmed, M.B. Recent Developments of Carboxymethyl Cellulose. Polymers 2021, 13, 1345. [Google Scholar] [CrossRef] [PubMed]
- Kanikireddy, V.; Varaprasad, K.; Jayaramudu, T.; Karthikeyan, C.; Sadiku, R. Carboxymethyl cellulose-based materials for infection control and wound healing: A review. Int. J. Biol. Macromol. 2020, 164, 963–975. [Google Scholar] [CrossRef]
- Pettignano, A.; Charlot, A.; Fleury, E. Carboxyl-functionalized derivatives of carboxymethyl cellulose: Towards advanced biomedical applications. Polym. Rev. 2019, 59, 510–560. [Google Scholar] [CrossRef]
- Hu, Y.; Hu, S.; Zhang, S. A double-layer hydrogel based on alginate-carboxymethyl cellulose and synthetic polymer as sustained drug delivery system. Sci. Rep. 2021, 11, 9142. [Google Scholar] [CrossRef]
- Verma, N.; Pramanik, K.; Singh, A.K.; Biswas, A. Design of magnesium oxide nanoparticle incorporated carboxy methyl cellulose/poly vinyl alcohol composite film with novel composition for skin tissue engineering. Adv. Perform. Mater. 2022, 37, 706–716. [Google Scholar] [CrossRef]
- Sadeghi, S.; Nourmohammadi, J.; Ghaee, A.; Soleimani, N. Carboxymethyl cellulose-human hair keratin hydrogel with controlled clindamycin release as antibacterial wound dressing. Int. J. Biol. Macromol. 2020, 147, 1239–1247. [Google Scholar] [CrossRef] [PubMed]
- Mansur, A.A.; de Carvalho, F.G.; Mansur, R.L.; Carvalho, S.M.; de Oliveira, L.C.; Mansur, H.S. Carboxymethylcellulose/ZnCdS fluorescent quantum dot nanoconjugates for cancer cell bioimaging. Int. J. Biol. Macromol. 2017, 96, 675–686. [Google Scholar] [CrossRef] [PubMed]
- Priya, G.; Madhan, B.; Narendrakumar, U.; Suresh Kumar, R.V.; Manjubala, I. In Vitro and In Vivo Evaluation of Carboxymethyl Cellulose Scaffolds for Bone Tissue Engineering Applications. ACS Omega 2021, 6, 1246–1253. [Google Scholar] [CrossRef]
- Wang, C.; Fadeev, M.; Zhang, J.; Vázquez-González, M.; Davidson-Rozenfeld, G.; Tian, H.; Willner, I. Shape-memory and self-healing functions of DNA-based carboxymethyl cellulose hydrogels driven by chemical or light triggers. Chem. Sci. 2018, 9, 7145–7152. [Google Scholar] [CrossRef]
- Teti, G.; Salvatore, V.; Focaroli, S. In vitro osteogenic and odontogenic differentiation of human dental pulp stem cells seeded on carboxymethyl cellulose-hydroxyapatite hybrid hydrogel. Front. Physiol. 2015, 6, 297. [Google Scholar] [CrossRef] [PubMed]
- Park, S.; Park, J.; Heo, J.; Lee, S.E.; Shin, J.W.; Chang, M.; Hong, J. Polysaccharide-based superhydrophilic coatings with antibacterial and anti-inflammatory agent-delivering capabilities for ophthalmic applications. J. Ind. Eng. Chem. 2018, 68, 229–237. [Google Scholar] [CrossRef]
- Melilli, G.; Carmagnola, I.; Tonda-Turo, C. DLP 3D Printing Meets Lignocellulosic Biopolymers: Carboxymethyl Cellulose Inks for 3D Biocompatible Hydrogels. Polymers 2020, 12, 1655. [Google Scholar] [CrossRef]
- Ghilan, A.; Chiriac, A.P.; Nita, L.E.; Rusu, A.G.; Neamtu, I.; Chiriac, V.M. Trends in 3D Printing Processes for Biomedical Field: Opportunities and Challenges. J. Polym. Environ. 2020, 28, 1345–1367. [Google Scholar] [CrossRef] [PubMed]
- Memic, A.; Abudula, T.; Mohammed, H.S.; Joshi Navare, K.; Colombani, T.; Bencherif, S.A. Latest progress in electrospun nanofibers for wound healing applications. ACS Appl. Bio. Mater. 2019, 2, 952–969. [Google Scholar] [CrossRef]
- Kaith, B.S.; Singh, A.; Sharma, A.; Sud, D. Synthesis, classification and properties of hydrogels: Their applications in drug delivery and agriculture. J. Mater. Chem. B 2022, 10, 170–203. [Google Scholar] [CrossRef]
- Chirani, N.; Yahia, L.; Gritsch, L.; Motta, F.L.; Chirani, S.; Fare, S. History and Applications of Hydrogels. J. Biomed. Sci. 2015, 4, 1–23. [Google Scholar] [CrossRef]
- Kono, H. Characterization and properties of carboxymethyl cellulose hydrogels crosslinked by polyethylene glycol. Carbohydr. Polym. 2014, 106, 84–93. [Google Scholar] [CrossRef]
- Tashi, Z.; Zare, M.; Parvin, N. Application of phytic-acid as an in-situ crosslinking agent in electrospun gelatin-based scaffolds for skin tissue engineering. Mater. Lett. 2020, 264, 127275. [Google Scholar] [CrossRef]
- Nita, L.E.; Chiriac, A.P.; Ghilan, A.; Rusu, A.G.; Tudorachi, N.; Timpu, D. Alginate enriched with phytic acid for hydrogels preparation. Int. J. Biol. Macromol. 2021, 181, 561–571. [Google Scholar] [CrossRef]
- Liu, G.; Liu, Z.; Li, J.; Zeng, M.; Li, Z.; He, L.; Li, F. Chitosan/phytic acid hydrogel as a platform for facile synthesis of heteroatom-doped porous carbon frameworks for electrocatalytic oxygen reduction. Carbon. 2018, 137, 68–77. [Google Scholar] [CrossRef]
- Han, D.; Zhao, H.; Gao, L.; Qin, Z.; Ma, Z.; Han, Y.; Jiao, T. Preparation of carboxymethyl chitosan/phytic acid composite hydrogels for rapid dye adsorption in wastewater treatment. Colloids Surf. A Physicochem. Eng. Asp. 2021, 628, 127355. [Google Scholar] [CrossRef]
- Zhang, S.; Zhang, Y.; Li, B.; Zhang, P.; Kan, L.; Wang, G.; Wei, H.; Zhang, X.; Ma, N. One-step preparation of highly stretchable, conductive and transparent polyvinyl alcohol-phytic acid hydrogel for casual writing circuits. ACS Appl. Mater. Interfaces 2019, 11, 32441–32448. [Google Scholar] [CrossRef] [PubMed]
- Bui, H.L.; Huang, C.J. Tough Polyelectrolyte Hydrogels with Antimicrobial Property via Incorporation of Natural Multivalent Phytic Acid. Polymers 2019, 11, 1721. [Google Scholar] [CrossRef]
- Zhang, Q.; Liu, X.; Zhang, J.; Duan, L.; Gao, G. A highly conductive hydrogel driven by phytic acid towards a wearable sensor with freezing and dehydration resistance. J. Mater. Chem. A 2021, 9, 22615–22625. [Google Scholar] [CrossRef]
- Pan, L.; Yu, G.; Zhai, D.; Lee, H.R.; Zhao, W.; Liu, N.; Wang, H.; Tee, B.C.; Shi, Y.; Cui, Y.; et al. Hierarchical nanostructured conducting polymer hydrogel with high electrochemical activity. Proc. Natl. Acad. Sci. USA 2012, 109, 9287–9292. [Google Scholar] [CrossRef] [PubMed]
- Narayanaswamy, R.; Wai, L.K.; Esa, N.M. Molecular Docking Analysis of Phytic Acid and 4-hydroxyisoleucine as Cyclooxygenase-2, Microsomal Prostaglandin E Synthase-2, Tyrosinase, Human Neutrophil Elastase, Matrix Metalloproteinase-2 and -9, Xanthine Oxidase, Squalene Synthase, Nitric Oxide Synthase, Human Aldose Reductase, and Lipoxygenase Inhibitors. Pharmacogn. Mag. 2017, 13, 512–518. [Google Scholar] [CrossRef]
- Rodoplu, S.; Celik, B.E.; Kocaaga, B. Dual effect of procaine-loaded pectin hydrogels: Pain management and in vitro wound healing. Polym. Bull. 2021, 78, 2227–2250. [Google Scholar] [CrossRef]
- Capanema, N.S.V.; Mansur, A.A.P.; de Jesus, A.C.; Carvalho, S.M.; de Oliveira, L.C.; Mansur, H.S. Superabsorbent crosslinked carboxymethyl cellulose-PEG hydrogels for potential wound dressing applications. Int. J. Biol. Macromol. 2018, 106, 1218–1234. [Google Scholar] [CrossRef] [PubMed]
- Rosso, N.D. Equilibrium, thermoanalytical and spectroscopic studies to characterize phytic acid complexes with Mn(II) and Co(II). J. Braz. Chem. Soc. 2009, 20, 1515–1522. [Google Scholar] [CrossRef]
- Lee, C.M.; Kubicki, J.D.; Fan, B.F.; Zhong, L.; Jarvis, M.C.; Kim, S.H. Hydrogen-Bonding Network and OH Stretch Vibration of Cellulose:Comparison of Computational Modeling with Polarized IR and SFG Spectra. J. Phys. Chem. B 2015, 119, 15138–15149. [Google Scholar] [CrossRef]
- Rusu, A.G.; Chiriac, A.P.; Nita, L.E.; Bercea, M.; Tudorachi, N.; Ghilan, A.G.; Pamfil, D.; Rusu, D.; Cojocaru, F.D. Interpenetrated polymer network with modified chitosan in composition and self-healing properties. Int. J. Biol. Macromol. 2019, 132, 374–384. [Google Scholar] [CrossRef]
- Tripathy, J.; Mishra, D.K.; Behari, K. Graft copolymerization of N-vinylformamide onto sodium carboxymethylcellulose and study of its swelling, metal ion sorption and flocculation behavior. Carbohydr. Polym. 2009, 75, 604–611. [Google Scholar] [CrossRef]
- Basu, P.; Narendrakumar, U.; Arunachalam, R.; Devi, S.; Manjubala, I. Characterization and evaluation of carboxymethyl cellulose-based films for healing of full-thickness wounds in normal and diabetic rats. ACS Omega 2018, 3, 12622–12632. [Google Scholar] [CrossRef]
- El-Sayed, S.; Mahmoud, K.; Fatah, A.; Hassen, A. DSC, TGA and dielectric properties of carboxymethyl cellulose/polyvinyl alcohol blends. Phys. B 2011, 406, 4068–4076. [Google Scholar] [CrossRef]
- ISO 10993-5:2009; Biological Evaluation of Medical Devices—Part 5: Tests for In Vitro Cytotoxicity. International Organization for Standardization: Geneva, Switzerland, 2009.
- Zhou, Q.; Zhao, Y.; Dang, H.; Tang, Y.; Zhang, B. Antibacterial Effects of Phytic Acid against Foodborne Pathogens and Investigation of Its Mode of Action. J. Food Prot. 2018, 82, 826–833. [Google Scholar] [CrossRef]
- Nassar, R.; Nassar, M.; Vianna, M.E.; Naidoo, N.; Alqutami, F.; Kaklamanos, E.G.; Senok, A.; Williams, D. Antimicrobial Activity of Phytic Acid: An Emerging Agent in Endodontics. Front. Cell. Infect. Microbiol. 2021, 11, 753649. [Google Scholar] [CrossRef]
- Korsmeyer, R.W.; Lustig, S.R.; Peppas, N.A. Solute and penetrant diffusion in swellable polymers. I. Mathematical modeling. J. Polym. Sci. Part B Polym. Phys. 1986, 24, 395–408. [Google Scholar] [CrossRef]
- Bauer, A.W.; Perry, D.M.; Kirby, V.M.M. Single disc antibiotic sensitivity testing of Staphylococci. A.M.A. Arch. Intern. Med. 1959, 104, 208–216. [Google Scholar] [CrossRef]
- Clinical and Laboratory Standards Institute (CLSI). Performance Standards for Antimicrobial Susceptibility Testing, 32nd ed.; CLSI supplement M100, ISBN1 978-1-68440-134-5 [Print]. ISBN2 978-1-68440-135-2 [Electronic]. Clinical and Laboratory Standards Institute: Wayne, PA, USA, 2022. [Google Scholar]
- XLSTAT|Statistical Software for Excel n.d. Available online: https://www.xlstat.com/en (accessed on 27 September 2022).








| Wavenumber, cm−1 | Type of Vibration | |||
|---|---|---|---|---|
| CMC_PA = 20:1 | CMC_PA = 10:1 | CMC_PA = 6:1 | ||
| 3457 | 3447 | 3435 | –OH | CMC- and PA-related stretching modes |
| 2932 | 2927 | 2927 | C–H | |
| 1742 | 1738 | 1734 | COOH | CMC-related stretching modes |
| 1645 | 1643 | 1641 | P=O | PA-related stretching modes |
| 1126 | 1130 | 1130 | P–O–C | |
| 1061–1007 | 1058–1012 | 1058–1012 | C–O and C-O-C | CMC-related stretching modes |
| Sample | Heating Rate °C/min | Degradation Stage | Tonset °C | Tpeak °C | W % | T20 °C | T25 °C |
|---|---|---|---|---|---|---|---|
| CMC | 10 | I II III IV residue | 35 229 356 536 | 78 285 408 569 | 12.55 29.96 10.23 8.90 38.36 | 263 | 274 |
| CMC_PA = 20:1 | 10 | I II III IV residue | 31 147 254 305 | 77 200 275 - | 2.39 15.93 11.00 13.04 57.64 | 264 | 281 |
| CMC_PA = 10:1 | 10 | I II III IV residue | 40 168 232 304 | 74 198 249 332 | 4.55 8.03 9.17 18.77 59.48 | 269 | 321 |
| CMC_PA = 6:1 | 10 | I II III IV residue | 45 156 215 303 | 75 180 238 334 | 3.52 4.48 10.79 23.07 58.14 | 301 | 341 |
| Sample Name | n | R2n | k [min −n] | R2k |
|---|---|---|---|---|
| CMC_PA = 20:1_1 | 0.229 | 0.9689 | 0.553 | 0.9976 |
| CMC_PA = 10:1_1 | 0.338 | 0.9917 | 0.347 | 0.9979 |
| CMC_PA = 10:1_2 | 0.344 | 0.9923 | 0.313 | 0.9932 |
| CMC_PA = 10:1_3 | 0.418 | 0.9814 | 0.278 | 0.9979 |
| CMC_PA = 10:1_4 | 0.381 | 0.9891 | 0.321 | 0.9965 |
| CMC_PA = 6:1_1 | 0.568 | 0.9844 | 0.188 | 0.9940 |
| S. aureus | E. coli | |||
|---|---|---|---|---|
| Inhibition Zone (mm) | Inhibition Zone (mm) | |||
| CMC_PA = 20:1 | 8.80 ± 0.28 | ![]() | 9.10 ± 1.69 | ![]() |
| CMC_PA = 10:1 | 10.60 ± 0.56 | 10.15 ± 1.06 | ||
| CMC_PA = 6:1 | 12.00 ± 0.42 | 17.50 ± 0.14 | ||
| Sample Code | CMC, mL | PA, µL |
| CMC_PA = 20:1 | 5 | 250 |
| CMC_PA = 10:1 | 5 | 500 |
| CMC_PA = 6:1 | 5 | 750 |
| Procaine-Loaded Samples | ||
| Sample Code | Hydrogel Sample, g | Procaine, g |
| CMC_PA = 20:1_P_1 | 0.036 | 0.0120 |
| CMC_PA = 10:1_P_1 | 0.036 | 0.0120 |
| CMC_PA = 10:1_P_2 | 0.036 | 0.0090 |
| CMC_PA = 10:1_P_3 | 0.036 | 0.0075 |
| CMC_PA = 10:1_P_4 | 0.036 | 0.0060 |
| CMC_PA = 6:1_P_1 | 0.036 | 0.0120 |
Publisher’s Note: MDPI stays neutral with regard to jurisdictional claims in published maps and institutional affiliations. |
© 2022 by the authors. Licensee MDPI, Basel, Switzerland. This article is an open access article distributed under the terms and conditions of the Creative Commons Attribution (CC BY) license (https://creativecommons.org/licenses/by/4.0/).
Share and Cite
Ghilan, A.; Nita, L.E.; Pamfil, D.; Simionescu, N.; Tudorachi, N.; Rusu, D.; Rusu, A.G.; Bercea, M.; Rosca, I.; Ciolacu, D.E.; et al. One-Step Preparation of Carboxymethyl Cellulose—Phytic Acid Hydrogels with Potential for Biomedical Applications. Gels 2022, 8, 647. https://doi.org/10.3390/gels8100647
Ghilan A, Nita LE, Pamfil D, Simionescu N, Tudorachi N, Rusu D, Rusu AG, Bercea M, Rosca I, Ciolacu DE, et al. One-Step Preparation of Carboxymethyl Cellulose—Phytic Acid Hydrogels with Potential for Biomedical Applications. Gels. 2022; 8(10):647. https://doi.org/10.3390/gels8100647
Chicago/Turabian StyleGhilan, Alina, Loredana Elena Nita, Daniela Pamfil, Natalia Simionescu, Nita Tudorachi, Daniela Rusu, Alina Gabriela Rusu, Maria Bercea, Irina Rosca, Diana Elena Ciolacu, and et al. 2022. "One-Step Preparation of Carboxymethyl Cellulose—Phytic Acid Hydrogels with Potential for Biomedical Applications" Gels 8, no. 10: 647. https://doi.org/10.3390/gels8100647
APA StyleGhilan, A., Nita, L. E., Pamfil, D., Simionescu, N., Tudorachi, N., Rusu, D., Rusu, A. G., Bercea, M., Rosca, I., Ciolacu, D. E., & Chiriac, A. P. (2022). One-Step Preparation of Carboxymethyl Cellulose—Phytic Acid Hydrogels with Potential for Biomedical Applications. Gels, 8(10), 647. https://doi.org/10.3390/gels8100647